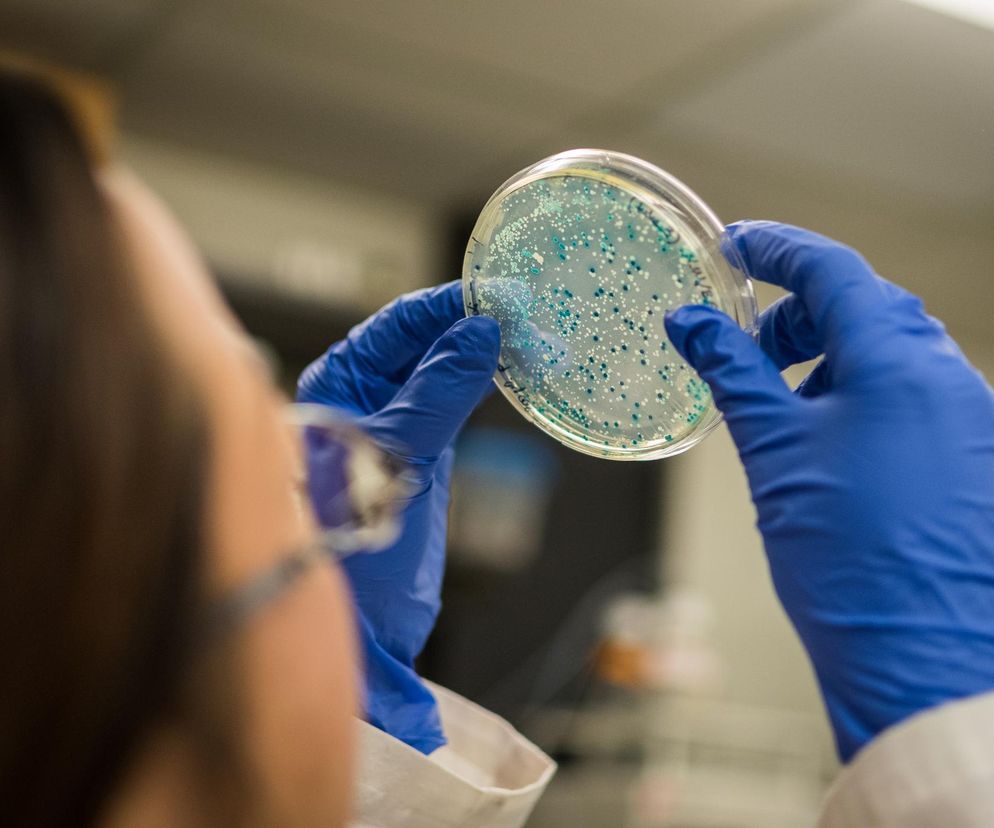

Enterokoki w wodzie. Nie wolno jej pić
We czwartek powiatowy sanepid w Szydłowcu poinformował o wykryciu bakterii z rodzaju Enterococcus w wodzie dostarczanej przez wodociąg miejski. W informacji zamieszczonej na FB zaznaczył, że woda wodociągowa z kranów nie nadaje się do spożycia. Można jedynie używać jej do spłukiwania urządzeń sanitarnych.
"Wykorzystywanie jej do picia, przygotowywania posiłków, kontakt z nią podczas mycia lub kąpieli stanowią zagrożenia dla zdrowia osób z niej korzystających" – zaznaczyły służby sanitarne.
Już w piątek miasto uruchomiło dystrybucję wody pitnej dla mieszkańców.
W niedzielę mieszkańcy od godz. 10 mogą zgłaszać się po wodę pitną do 6 punktów dystrybucji. Są one zorganizowane w trzech szkołach, w Wodociągach Miejskich, na placu OSP i na parking przy SP ZZOZ przy ul. Staszica, a także w trzech wsiach: Długosz, Świerczek i Szydłówek I.
Woda rozdawana jest w pięciolitrowych pojemnikach i w litrowych workach foliowych.
Szydłowiecki magistrat poinformował, że osoby, które nie mogą samodzielnie odebrać wody, mogą zawiadomić o tym telefonicznie biuro zarządzania kryzysowego Urzędu Miejskiego w Szydłowcu. Woda zostanie im dostarczona do domu przez służby miejskie.
Enterokoki mogą wywoływać groźne choroby
Bakterie z rodzaju Enterococcus wchodzą w skład ludzkiej mikroflory bakteryjnej i zazwyczaj nie stanowią zagrożenia, jednak gdy ich liczba zwiększa się w niekontrolowany sposób, mogą wywoływać poważne choroby.
Najlepiej poznane są Enterococcus faecalis (paciorkowiec kałowy) bytujący w układzie pokarmowym, i Enterococcus faecium. Paciorkowiec kałowy, przeniesiony w okolice jamy ustnej, może doprowadzić do rozwoju infekcji.
Enterokokami można się zakazić w różnych miejscach (w tym w szpitalach) - do zakażenia dochodzi najczęściej w wyniku braku higieny osobistej, dlatego są one określane często jako "bakterie brudnych rąk". Źródłem enterokoków może być też zakażona woda.
Bakterie te mogą wywoływać szereg różnych chorób, w tym:
- zapalenie nerek
- zapalenie pęcherza moczowego
- zapalenie gruczołu krokowego u mężczyzn
- zapalenie płuc
- zapalenie wsierdzia
- zapalenie stawów i kości
- infekcje układu oddechowego.
Gdy przedostaną się do krwiobiegu, mogą wywoływać posocznicę.
Leczenie zakażeń wywoływanych przez enterokoki może być bardzo trudne, są one bowiem dporne na wiele stosowanych obecnie antybiotyków.
Listen on Spreaker.